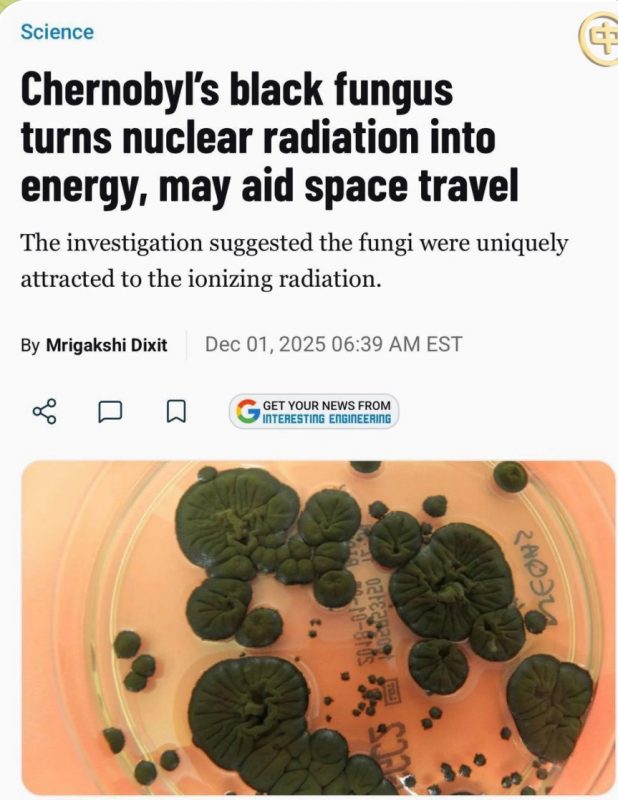
На території ЧАЕС виявлено грибок Cladosporium sphaerospermum, який не тільки витримує екстремальну радіацію, а й перетворює її на енергію, — Interesting Engineering

Вчені вбачають у цьому можливості для космічних технологій: біологічний щит можна вирощувати безпосередньо в космосі, що робить його легшою та економічнішою альтернативою традиційним матеріалам.
Вчені вбачають у цьому можливості для космічних технологій: біологічний щит можна вирощувати безпосередньо в космосі, що робить його легшою та економічнішою альтернативою традиційним матеріалам.
Всі права захищені.
При будь-якому використанні матеріалів посилання на 33kanal.com є обов'язковим.